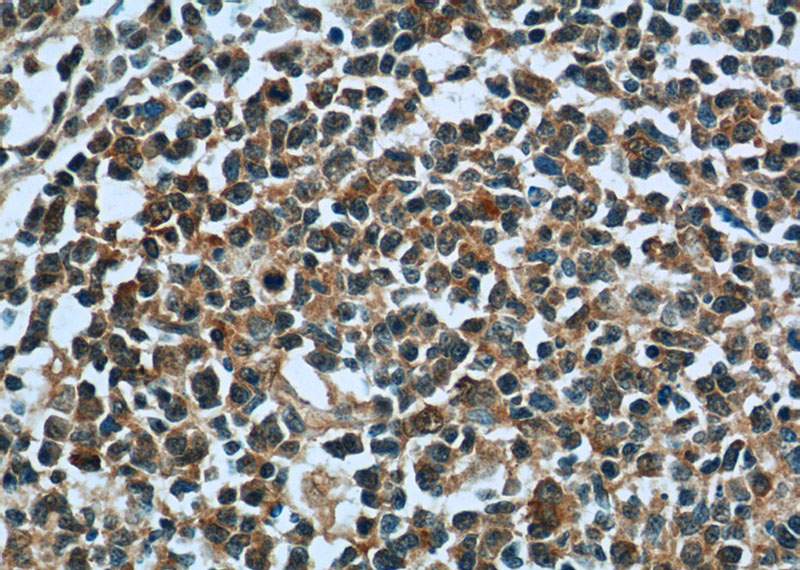
Immunohistochemistry of paraffin-embedded human tonsillitis tissue slide using Catalog No:116383(TTC37 Antibody) at dilution of 1:50 (under 40x lens)
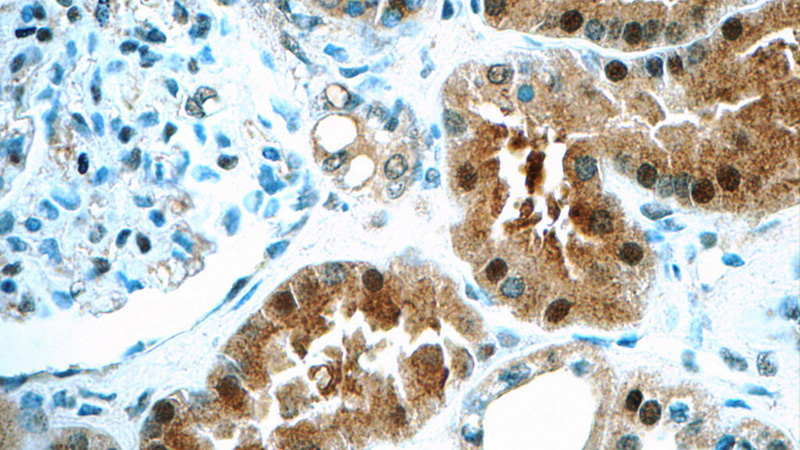
Immunohistochemistry of paraffin-embedded human kidney tissue slide using Catalog No:116383(TTC37 Antibody) at dilution of 1:50 (under 40x lens)

-
Product Name
TTC37 antibody
- Documents
-
Description
TTC37 Rabbit Polyclonal antibody. Positive IF detected in HepG2 cells. Positive IHC detected in human kidney tissue, human tonsillitis tissue. Positive WB detected in HeLa cells, HEK-293 cells, MCF-7 cells, mouse testis tissue. Observed molecular weight by Western-blot: 140-150 kDa
-
Tested applications
ELISA, WB, IHC, IF
-
Species reactivity
Human, Mouse; other species not tested.
-
Alternative names
KIAA0372 antibody; TPR repeat protein 37 antibody; TTC37 antibody
-
Isotype
Rabbit IgG
-
Preparation
This antibody was obtained by immunization of TTC37 recombinant protein (Accession Number: XM_047417937). Purification method: Antigen affinity purified.
-
Clonality
Polyclonal
-
Formulation
PBS with 0.1% sodium azide and 50% glycerol pH 7.3.
-
Storage instructions
Store at -20℃. DO NOT ALIQUOT
-
Applications
Recommended Dilution:
WB: 1:200-1:1000
IHC: 1:20-1:200
IF: 1:10-1:100
-
Validations

HeLa cells were subjected to SDS PAGE followed by western blot with Catalog No:116383(TTC37 Antibody) at dilution of 1:300
Immunohistochemistry of paraffin-embedded human tonsillitis tissue slide using Catalog No:116383(TTC37 Antibody) at dilution of 1:50 (under 40x lens)
Immunohistochemistry of paraffin-embedded human kidney tissue slide using Catalog No:116383(TTC37 Antibody) at dilution of 1:50 (under 40x lens)

Immunofluorescent analysis of HepG2 cells using Catalog No:116383(TTC37 Antibody) at dilution of 1:25 and Rhodamine-Goat anti-Rabbit IgG
-
Background
TTC37 (tetratricopeptide repeat protein 37), also named as Thespin, encodes 1,564 amino acid protein that contains twenty tetratricopeptide (TPR) repeats. TPR repeat-containing motifs are found in a variety of proteins and may mediate protein-protein interactions and chaperone activity. Although not expressed in liver, TTC37 is a widely expressed protein with highest levels of expression in vascular tissues, lymph node, pituitary, lung and intestine. TTC37 is a component of the SKI complex which is thought to be involved in exosome-mediated RNA decay and associates with transcriptionally active genes in a manner dependent on PAF1 complex (PAF1C). Defects in TTC37 are associated with Trico-Hepato-Enteric (THE) syndrome.
-
References
- Kohda M, Tokuzawa Y, Kishita Y. A Comprehensive Genomic Analysis Reveals the Genetic Landscape of Mitochondrial Respiratory Chain Complex Deficiencies. PLoS genetics. 12(1):e1005679. 2016.
Related Products / Services
Please note: All products are "FOR RESEARCH USE ONLY AND ARE NOT INTENDED FOR DIAGNOSTIC OR THERAPEUTIC USE"
